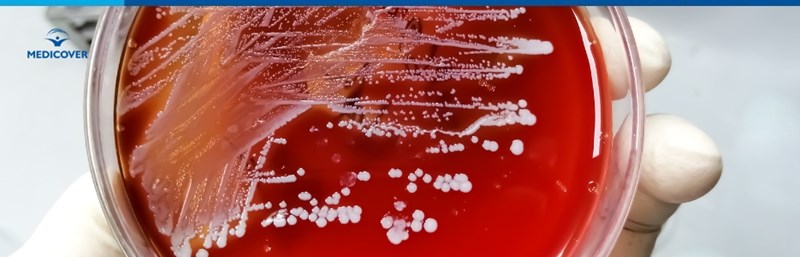

Exista insa si situatii in care acest patogen bacterian cauzeaza infectii comunitare sau nozocomiale (de spital) cu diferite localizari la nivelul organismului, care apar in urma actiunii unui cumul de factori de risc ce pot tine de mediu sau persoana in cauza. S.aureus constituie patogenul bacterian cel mai frecvent implicat in aparitia infectiilor la om care includ endocardita, impetigo, foliculita, furunculoza, carbunculoza, celulita, sindromul pielii oparite, osteomielita, artrita septica, pneumonii si nu numai.
Cuprins
- Cum se transmite infectia cu Staphylococcus aureus?
- Factori de risc
- Semne si simptome ale infectiei cu stafilococ auriu
- Infectia cu stafilococ auriu la copii
- Diagnostic infectie cu stafilococ auriu
- Tratament infectie cu stafilococ auriu
- Rezistenta stafilococului auriu la antibiotice
- Complicatii infectie cu stafilococ auriu
Sumar: Stafilococul auriu poate coloniza organismul fara simptome, dar uneori provoaca infectii severe. |
Cum se transmite infectia cu Staphylococcus aureus?
S.aureus se poate raspandi fie prin contactul direct cu o persoana bolnava, fie prin atingerea obiectelor contaminate de catre aceasta (echipament de sport, telefon mobil, clanta, butoane ale liftului, tastatura). Mai putin intalnita este situatia in care S.aureus se transmite pe calea aerului (transmitere aerogena) prin inhalarea de picaturi Pflugge eliminate de la nivel respirator in timpul stranutului sau tusitului.
Factori de risc
Statusul de purtator sanatos de S.aureus pe care il au anumite persoane care lucreaza in domeniul medical creste riscul de transmitere al patogenului implicat in aparitia infectiilor stafilococice prin mobilizarea acestuia de la nivelul mucoasei nazale pe suprafata tegumentelor.
Alti factori de risc care contribuie la aparitia infectiilor stafilococice includ:
- Spitalizarea pentru perioade indelungate de timp
- Asocierea unui sistem imun debilitat sau a unei patologii cu evolutie cronica (fibroza chistica, emfizem pulmonar, leucemie, diabet zaharat)
- Existenta unei solutii de continuitate la nivel tegumentar (incizie chirurgicala, leziune traumatica)
- Consumul de alimente contaminate cu S.aureus
- Necesitatea efectuarii unui implant protetic (proteze ortopedice, valve cardiace) sau a tratamentelor care implica dializa pentru insuficienta renala in stadiu terminal.
Convietuirea cu o persoana care prezinta colonizare la nivel nazal sau tegumentar cu S.aureus, ingrijirea bolnavilor cu stafilococie si utilizarea de droguri cu administrare intravenoasa constituie alti factori de risc care contribuie la aparitia infectiilor cu acest patogen. Afla mai multe depre infectiile stafilococice
Semne si simptome ale infectiei cu stafilococ auriu
Manifestarile de ordin sistemic ale infectiilor cu S.aureus implica stare generala alterata, inflamatie, febra si frisoane la care se adauga simptome specifice de organ/sistem in functie de localizarea bacteriei in organism.
- Infectiile pielii cu aureus asociaza de regula inflamatie, eritem (inrosirea pielii), disconfort dureros, edem si constituirea de leziuni tegumentare care pot include blistere (basici cu lichid), pustule sau furuncule. Sindromul pielii oparite sau pemfigusul neonatal constituie o stafilococie a pielii care afecteaza nou-nascutii si se manifesta prin eritem cutanat difuz, desprinderea stratului superficial al pielii (ca in cazul unei arsuri termice), blistere cu lichid sau continut purulent, disconfort dureros, sindrom febril si letargie a sugarului.
- Sindromul socului toxic generat de S.aureus afecteaza cu precadere persoanele de sex feminin care utilizeaza tampoane interne in timpul menstruatiei, patologia avand risc inalt de evolutie nefasta (intre 30-70% din cazuri se soldeaza cu decesul pacientei) in cazul in care este diagnosticata tardiv sau nu se instituie tratament corespunzator.
- Pneumonia stafilococica asociaza de regula frisoane cu debut brusc, febra inalta, dispnee si secretii respiratorii mucopurulente pe care pacientul le expectoreaza la finalul acceselor de tuse. Infectiile pulmonare datorate tulpinilor de S.aureus pot evolua complicat cu aparitia necrozei pulmonare, a bacteriemiei (diseminarea patogenului bacterian la nivel circulator), empiem si sepsis cu sau fara soc.
- Endocardita stafilococica reprezinta o boala cu risc inalt de evolutie nefasta (mortalitatea este cuprinsa intre 30 si 40%) care poate afecta atat persoanele cu patologii valvulare preexistente, cat si indivizii sanatosi cu functie cardiaca indemna. Principalele manifestari care intra in alcatuirea endocarditei stafilococice sunt reprezentate de febra, frisoane, transpiratii, dispnee de tip inspirator la efort fizic moderat (sau in conditii de repaus, in functie de severitatea infectiei), dereglari ale ritmului cardiac, fatigabilitate si scadere ponderala neintentionata.
- Toxiinfectia alimentara cu S.aureus se caracterizeaza din punct de vedere clinic prin senzatie de greata, varsaturi, durere abdominala si diaree care debuteaza la scurt timp dupa ingestia de alimente contaminate.

Infectia cu stafilococ auriu la copii
Cele mai frecvente patologii ale copilului cauzate de catre S.aureus include:
- Foliculita
- Furunculoza
- Impetigo
- Celulita
- Orjelet (ulcior la ochi)
- Otita
- Sindromul pielii oparite a nou-nascutului
- Infectiile plagilor superficiale (zgarieturi, julituri, arsuri, taieturi)
- Toxiinfectia alimentara.
Sistemul imunitar incomplet dezvoltat, igiena necorespunzatoare a mainilor si contactul cu altii copii bolnavi din cadrul comunitatilor scolare constituie principalii factori de risc care predispun populatia pediatrica la aparitia infectiilor stafilococice. Din punct de vedere clinic, infectiile stafilococice ale copilului sunt marcate de 2 factori de gravitate:
- Frecventa rezistentei la antibiotice.
- Adaptabilitatea germenului bacterian la mediu si capacitatea acestuia de a suferi mutatii rapide.
Punctul de plecare al primoinfectiei stafilococice in primul an de viata al sugarului si ulterior, la copiii mai mari, este reprezentat de infectia tegumentelor si al altor tesuturi care includ impetigo, furunculoza, paronichia si celulita. Aditional acestora, nou-nascutul mai poate prezenta infectii stafilococice localizate, de tipul omfalitei (infectia ombilicului si a tesuturilor din jurul acestuia) si mastitei (inflamatie a glandei mamare care apare de regula in prima luna de viata a sugarului).
Diagnostic infectie cu stafilococ auriu
Diagnosticul infectiior cauzate de S.aureus se realizeaza prin efectuarea de culturi din produsele biologice (sputa, secretie otica, vaginala, secretie plaga, lichide de punctie, materii fecale) ale pacientului in laboratorul de bacteriologie. In cazul in care medicul curant suspecteaza existenta unei bacteriemii, acesta poate recomanda realizarea de hemoculturi seriate in vederea izolarii agentului patogen. Real time PCR reprezinta o alternativa rapida de diagnosticare a infectiilor stafilococice cu diferite localizari la nivelul organismului, care se bazeaza pe identificarea ARN ului bacterian din probele biologice ale pacientului.
Formular de programare
Tratament infectie cu stafilococ auriu
Tratamentul infectiilor cu S.aureus este etiologic si presupune administrarea de antibiotice in conformitate cu susceptibilitatea (sensibilitatea) germenului la diferite clase de antibioterapice. Durata tratamentului si modalitatea de administrare a acestuia depinde de severitatea manifestarilor si extinderea infectiei la nivelul organismului. Stafilococii meticilino sensibili beneficiaza de regula de tratament antibiotic cu penicline, in timp ce tulpinile de MRSA necesita administrare de trimetoprim sulfametoxazol, clindamicina, doxiciclina, minociclina, linezolid sau vancomicina pentru eradicarea infectiei.
Alaturi de tratamentul medicamentos specific stafilocociilor, in anumite situatii poate fi necesara interventia chirurgicala pentru indepartarea tesuturilor necrozate sau inlocuirea dispozitivelor medicale contaminate (catetere venoase/centrale, proteze valvulare, proteze ortopedice, sterilet) la nivelul carora s-au identificat vegetatii bacteriene.
Rezistenta stafilococului auriu la antibiotice
Sensibil initial in 1952 la peniciline, stafilococul auriu a dobandit rezistenta pe parcursul urmatorilor 30 de ani prin mutatii succesive care la momentul actual sunt prezente in peste 90% din totalitatea tulpinilor de stafilococ auriu implicate in diverse patologii ale omului. Meticilino rezistenta stafilococului auriu ingreuneaza managementul terapeutic al pacientilor cu astfel de infectii, in special in cazul celor care asociaza bacteriemii cu MRSA.
Epidemiile nosocomiale apar ca urmare a persistentei indelungate pe mainile personalului medical si in mediul spitalicesc a tulpinilor de stafilococ multidrug rezistent care apar ca urmare a multitudinii de antibiotice administrate in spital si afecteaza mai frecvent pacientii din sectiile de arsi, ATI, oncologie, hemodializa si chirurgie.
Complicatii infectie cu stafilococ auriu
Principalele complicatii ale infectiilor cu SA implica bacteriemia, endocardita bacteriana, artrita septica, abcesele profunde de tesut moale, atacul cerebral cu emboli bacterieni, socul septic si decesul.
Recidivarea infectiei poate fi luata in considerare in situatia in care simptomatologia clinica reapare dupa finalizarea schemei de tratament in decurs de maxim 90 de zile de la primoinfectia bacteriana.
Principalele masuri de preventie ale infectiilor cauzate de S.aureus includ:
- Igienizarea frecventa a mainilor si uscarea acestora cu prosoape de hartie de unica folosinta.
- Utilizarea dezinfectantilor de maini pe baza de alcool.
- Ingrijirea corespunzatoare a plagilor prin mentinerea curata a acestora si acoperirea lor cu bandaje ocluzive sterile pana la vindecare.
- Evitarea utilizarii in comun cu alte persoane a obiectelor personale - prosoape, aparate de ras, aparate de tuns, haine.
- Igienizarea corecta a aparatelor de exercitii din salile de sport, atat inainte cat si dupa utilizarea acestora.
- Igienizarea regulata a suprafetelor frecvent atinse de catre copiii din colectivitatile prescolare si scolare; dezinfectarea telefoanelor mobile, a tastaturilor, clantelor, si al altor suprafete frecvent atinse.
- Retragerea din colectivitate a copiilor diagnosticati cu infectii stafilococice.
- Evitarea consumului de alimente depozitate in conditii necorespunzatoare sau vechi care prezinta aspect macroscopic si miros modificat.
- Schimbarea periodica a tampoanelor intravaginale si manipularea acestora numai dupa igienizarea riguroasa a mainilor.
- Acoperirea gurii si a nasului cu un servetel de hartie in timpul stranutului sau tusitului sau utilizarea plicii cotului pentru e preveni transmiterea aerogena a patogenului.
- Evitarea consumului de droguri intravenoase si efectuarea de tatuaje cu ace nesterile.
Referinte:
- Clinical identifiers of complicated Staphylococcus aureus bacteremia, Vance G. Fowler Jr. , Maren K. Olsen, G. Ralph Corey, Christopher W. Woods, Christopher H. Cabell, L. Barth Reller, Allen C. Cheng, Tara Dudley, Eugene Z. Oddone
- Patient education: Methicillin-resistant Staphylococcus aureus (MRSA) (Beyond the Basics)
- Staphylococcus aureus Infections, Larry M. Bush
- Staphylococcus aureus Infection, Tracey A. Taylor, Chandrashekhar G. Unakal
- Staph Infections, Cynthia C. Roque
- Staph infection, NHS
- Staph Infection and Cellulitis
- Staph infections in the hospital
- The Utility of Risk Factors to Define Complicated Staphylococcus aureus Bacteremia in a Setting With Low Methicillin-Resistant S. aureus Prevalence, Clinic Infectious Diseases | Oxford Academic
Intrebari Frecvente (FAQ)
Cum se transmite stafilococul auriu?
Transmiterea se face prin contact direct cu persoane infectate sau prin atingerea obiectelor contaminate, iar mai rar prin aer prin picaturi eliminate la stranut sau tuse.
Care sunt semnele unei infectii cu stafilococ auriu?
Poate provoca inflamatie, febra, frisoane si, in functie de localizare, leziuni ale pielii, pneumonie, endocardita sau toxiinfectie alimentara.
Cum se trateaza infectia cu stafilococ auriu?
Tratamentul consta in antibiotice alese dupa sensibilitatea bacteriei, iar in unele situatii poate fi necesara interventie chirurgicala pentru indepartarea tesuturilor afectate sau a dispozitivelor contaminate.